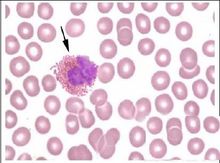
嗜酸粒细胞病理图 嗜酸粒细胞病理图

嗜酸粒细胞增多症(eosinophilia)是指外周血中嗜酸粒细胞绝对值大于(0.4~0.45)×109/L(400~450/mm3)。临床上常与多种疾病相关,特别是寄生虫感染、过敏性疾病、结缔组织病和肿瘤的非特异性反应等。嗜酸粒细胞增多症根据嗜酸粒细胞增多的程度分为轻度:嗜酸粒细胞(0.4~1.5)×109/L;中度:嗜酸粒细胞(1.5~5)×109/L;重度:嗜酸粒细胞>5×109/L。
-
简介
嗜酸性细胞增多的发生具有免疫反应的特征:使用旋毛(线)虫初次刺激可引起一个初级的且相当低水平的反应;然而重复刺激导致一扩增的或继发的嗜酸性细胞增多的反应。
-
病因
嗜酸性粒细胞增多症的病因:2.寄生虫病 为引起嗜酸性粒细胞增多最常见的病因之一。原虫(疟原虫、弓形虫、肺囊虫)、蠕虫(蛲虫蛔虫、钩虫、旋毛虫丝虫、肝毛细线虫)、吸虫(血吸虫、肺吸虫、中华分支睾吸虫)、绦虫以及疥虫和穿皮潜蚤的感染均可引起嗜酸性粒细胞增多。一般说来,肠道中成虫并不引起明显嗜酸性粒细胞增多,蚴虫移行时侵入各脏器,或肠道成虫破坏肠黏膜时 或寄生于肠道外组织的成虫会引起嗜酸性粒细胞明显增多。所以 外周血中嗜酸性粒细胞增多时,大便中不一定能找到虫卵。3.药物 一些药物如青霉素、链霉素、头孢菌素、对氨水杨酸、磺胺、苯妥英钠、氯丙嗪、肝精(肝浸膏) 碘剂、金剂、粒-巨噬细胞集落刺激因子等可引起中度甚至重度嗜酸性粒细胞增多,临床上可无药物过敏的其他症状。4.感染 某些感染如结核特别是淋巴结干酪样结核、猫抓病、传染性单核细胞增多症、猩红热、多形性红斑的急性期、艾滋病、念珠菌感染等都可使嗜酸性粒细胞增多。有的于感染极期嗜酸性粒细胞减少,而于恢复期暂时增多称为感染后反跳性嗜酸性粒细胞增多5.皮肤病湿疹、剥脱性皮炎、疱疹样皮炎、天疱疮 银屑病、红糠疹、鱼鳞癣等嗜酸性粒细胞可中度增多。6.血液病慢性粒细胞白血病、真性红细胞增多症、急性白血病、霍奇金病、非霍奇金淋巴瘤、血管免疫母细胞淋巴结病、恶性组织细胞病、系统性肥大细胞病、多发性骨髓瘤、γ重链病等可伴嗜酸性粒细胞增多。嗜酸性粒细胞白血病患者嗜酸性粒细胞重度增多,其形态亦异,表现为大小不一,颗粒粗大、分布不匀,并夹杂有嗜碱性颗粒,胞质中可有空泡,核分叶过多或过少,或有Dǒhle小体 应注意有的急性白血病细胞胞质呈金黄色、颗粒大,类似嗜酸性粒细胞,称为假性嗜酸性粒细胞8.风湿性疾病系统性红斑狼疮、类风湿关节炎、皮肌炎、血管炎、结节性多动脉炎、舍格伦综合征等可有嗜酸性粒细胞增多 常反映疾病的活动度 类风湿关节炎伴嗜酸性粒细胞增多者除有严重关节畸形外,易发生关节外病变如血管炎胸膜炎、皮下结节,血中补体减低、类风湿因子滴度显著增高。嗜酸性筋膜炎亦常致嗜酸性粒细胞增多。9.内分泌疾病 单一性腺垂体功能不全、肾上腺皮质功能减退症可见嗜酸性粒细胞增多。10.嗜酸性粒细胞增生性淋巴肉芽肿 多发生于青 壮年 男多于女。累及浅表淋巴结,表现为一组或多组或全身淋巴结肿大 亦可累及皮肤、腮腺、乳腺、肌肉等形成肿块,无骨 骼病变。发病缓慢,病程长。皮肤瘙痒,色素沉着,可有丘疹状角化增生。白细胞数正常或增多,分类:嗜酸性粒细胞常占10%以上,可高达77% 对放射敏感,皮质激素治疗亦有效 个别患者可转化为霍奇金病嗜酸粒细胞增多症需与朗汉斯细胞肉芽肿病(Langerhans cell granulomatosis)相鉴别,后者一般发生于小儿及青少年 多累及软组织及骨骼,病变局限显示有泡沫样组织细胞增生伴嗜酸性粒细胞浸润,而外周血中嗜酸性粒细胞一般不增多。11.家族性嗜酸性粒细胞增多 常染色体显性遗传,良性,同一家族中有多例。嗜酸性粒细胞增多终身存在,但健康状况良好,不需治疗。有报告合并再生障碍性贫血者 有的尚有血小板减少和桡骨缺如 也有家族性组织细胞增多伴嗜酸性粒细胞增多。13.嗜酸性粒细胞增多综合症(esinophilia) 为一组可急性、慢性、良性或恶性,累及一个或多个脏器,症状、体征有重叠的嗜酸性粒细胞增多的疾病的统称。指特发性嗜酸性粒细胞增多综合征而言。
-
发病机制
已知促嗜酸性粒细胞增多的细胞因子有白细胞介素-3(IL-3)、IL-5和粒-巨噬细胞集落刺激因子(granulocyte-macrophage colony stimulating factor,GM-CSF)。IL-3和GM-CSF除作用于嗜酸性粒细胞外 尚可作用于其他骨髓细胞系,而IL-5只刺激嗜酸性粒细胞生成。机体受内、外 因子刺激,激活T细胞,特别是辅助性T细胞,释放IL-5及少量GM-CSF刺激骨髓,生成嗜酸性粒细胞增多。嗜酸性粒细胞本身有IL-5mRNA转录,表达免疫组化能检出的IL-5蛋白。此外,嗜酸性粒细胞亦能分泌IL-3和GM-CSF,使嗜酸性粒细胞进一步增多。这也可解释有的嗜酸性粒细胞增多者,中性粒细胞也增多。嗜酸性粒细胞增多特别是特发性嗜酸性粒细胞增多综合征中有特异性器官损害。嗜酸性粒细胞特异性颗粒含4种阳离子:过氧化物酶、主要碱性蛋白(MBP) 嗜酸性粒细胞阳离子蛋白(ECP)及乙二醇二硝酸酯(EDN),均有细胞毒性。嗜酸性粒细胞代谢过程中生成氧化性产物,其单独或与过氧化物酶联合作用进一步引起氧介导损害,破坏细胞。嗜酸性粒细胞还能产生多种引起炎症及纤维化的因子如转化生长因子α和β(TGF-α,TGF-β)、肿瘤坏死因子α(TNF-α)、巨噬细胞炎性蛋白1α(macrophage inflammatory protein 1α MIP-1α)、IL-lα IL-6和IL-8等。嗜酸性粒细胞增多综合征患者血中有一种可被IL-5抗体中和的IL-5样物质,可延长嗜酸性粒细胞的生存。以上这些因子联合作用引起器官损害,最突出的器官受损为心脏,终致血栓形成及纤维化。嗜酸性粒细胞积聚于心脏通过与ICAM-1,ICAM-2,VCAM E-Selectin和P-selectin结合黏附于心内膜或心脏微血管内皮。嗜酸性粒细胞颗粒的阳离子蛋白可沉积于心内膜与心肌。嗜酸性粒细胞衍生的氧化基团可破坏内皮,其阳离子蛋白MBP等可激活血小板,使血液凝固性增强。嗜酸性粒细胞增多患者的单核细胞促凝活性增强,易使血栓形成。深部静脉血栓形成少见,而心内膜、小静脉及视网膜静脉血栓形成多见嗜酸性粒细胞阳离子蛋白可刺激成纤维细胞增生,抑制成纤维细胞对蛋白氨基多糖的降解,嗜酸性粒细胞分泌的TGF-α和TGF-β,分别促使成纤维细胞增生和细胞外基质沉积,进一步使细胞组织纤维化。至于嗜酸性粒细胞性胃肠炎和嗜酸性粒细胞性肺炎等无心脏损害,原因不清。嗜酸性粒细胞阳离子蛋白、嗜酸性粒细胞衍生的神经毒素可引起神经系统损害。
-
临床表现
表现
并发症
不同的病因可引发不同的并发症,如哮喘、荨麻疹、疮疹样皮炎等。 -
诊断
外周血嗜酸粒细胞绝对值增高即可诊断嗜酸粒细胞增多症,关键在于病因诊断。必须详细全面检查,以确定原发病,对诊断不肯定者应定期随访。
鉴别诊断
对嗜酸粒细胞增多症进行病因鉴别,应详细、全面地询问病史。如曾到过蠕虫感染流行区旅游则应考虑血吸虫等寄生虫感染;表现为喘气、鼻炎或湿疹则提示变异性疾病;经常接触宠物狗,则要排除犬弓蛔虫感染;注意有无肿瘤的症状,体征;注意用药史,以排除药物的过敏反应。由药物引起的嗜酸粒细胞增多,一般会随着停药而降低,但在某些病例 如由于摄入污染的色氨酸引起的嗜酸粒细胞-肌痛综合征,尽管停止了用药,疾病还会持续存在。异常的嗜酸粒细胞形态学,骨髓或外周血未成熟细胞的增加,或核型的异常都提示嗜酸粒细胞白血病。嗜酸粒细胞的聚集、浸润限定于特定的器官,是特殊疾病的特性,如嗜酸粒细胞蜂窝织炎(Well综合征),嗜酸粒细胞肺炎,以及嗜酸粒细胞筋膜炎。嗜酸粒细胞增多同时合并脉管炎、神经系统疾病和哮喘病史,提示Churg-Strauss综合征。在中度到重度嗜酸粒细胞增高的患者,如果找不到明确的病因,同时又有脏器的损害,则应考虑高嗜酸细胞结合症(HES)。对嗜酸粒细胞计数中度到重度增多,以及持续轻度增多的患者应进行血涂片的形态学检查,尿液分析和一系列的大便虫卵和寄生虫检查。对于粪类圆线虫等寄生虫的诊断有时需血清学试验。骨髓、染色体分析和组织活检可根据病情做出选择。实验室检查
外周嗜酸细胞占白细胞分类计数>4% 绝对值>0.45×109/L。其它辅助检查
根据临床表现、症状、体征结合病史、可选择做抗校抗体、抗DNA、抗ENA血清学检查,骨穿组织活检、心电图、X线、B超、CT、MRI等检查。 -
治疗及预后
治疗
嗜酸粒细胞增多症应以治疗原发病为主,若由寄生虫过敏引起,只要去除病因,不需特殊治疗,预后就很好,若患者有脏器受损,则不管嗜酸粒细胞增多的程度,均应给予降低嗜酸粒细胞计数或阻断嗜酸粒细胞效应的治疗。此外,还要根据病情做出相应支持,对症处理。若由恶性肿瘤引起或是嗜酸粒细胞白血病,则预后差。预后
与病因有关 如寄生虫、变应性、药物等所致,只要去除病因,不需特殊治疗,即可恢复。如是恶性肿瘤或嗜酸粒细胞白血病所致,则预后差